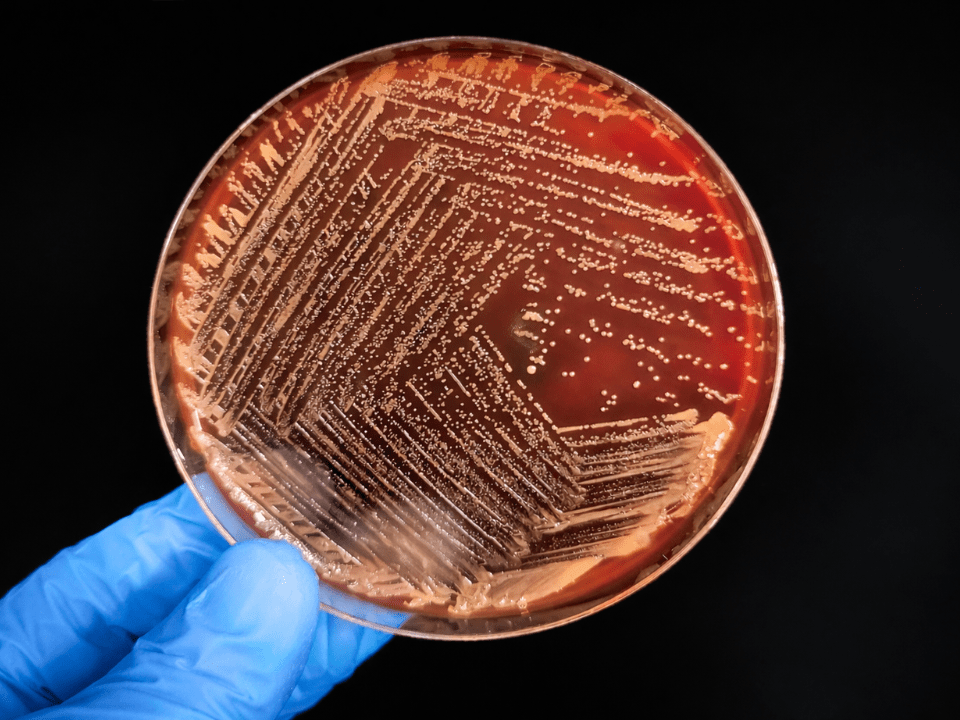
Placa de Petri com crescimento bacteriano em meio de cultura, representando o contexto laboratorial do teste molecular rápido para sepse e a investigação de infecção sanguínea.

Sepse é uma emergência médica que exige diagnóstico e tratamento imediatos para reduzir o risco de falência de órgãos e mortalidade, um desafio que tradicionalmente depende de hemoculturas, um método considerado padrão ouro, mas que leva dias para fornecer resultados e nem sempre é sensível o bastante para detectar todos os casos reais de infecção no sangue. Estudos epidemiológicos e clínicos mostram que mais de 90% de todas hemoculturas coletadas retornam negativas e apenas cerca de metade dos pacientes com sepse confirmado retrospectivamente apresentam culturas positivas, deixando lacunas importantes na tomada de decisão clínica.
Um estudo recém-publicado apresenta dados robustos que ligam de forma significativa os resultados de um teste molecular rápido, o SeptiCyte RAPID®, à probabilidade de hemoculturas positivas em pacientes com sepse, abrindo caminho para diagnóstico mais ágil e potencialmente mais preciso. A publicação é fruto de uma análise retrospectiva pós-hoc de dados coletados em três coortes prospectivas internacionais, envolvendo mais de 500 pacientes criticamente enfermos em ambientes de terapia intensiva e cuidados agudos.
Os achados revelam que escores elevados no teste molecular, obtidos em cerca de 90 minutos após a coleta de sangue, estão fortemente associados à positividade em hemoculturas, sugerindo que esta ferramenta pode identificar, em tempo real, aqueles pacientes com maior probabilidade de uma infecção bacteriana sistêmica detectável por cultura. Esta associação pode influenciar decisões clínicas, incluindo a necessidade de monitoramento intensivo ou ajustes precoces na terapêutica antimicrobiana, em um cenário no qual cada hora conta para o prognóstico do paciente.
Testes moleculares para sepse já são reconhecidos por oferecerem resultados substancialmente mais rápidos do que as culturas tradicionais, com potencial para reduzir o uso desnecessário de antibióticos e acelerar a intervenção em casos verdadeiros de infecção. Estudos sistemáticos e revisões comparativas apontam que métodos baseados na detecção do material genético de microorganismos têm alta especificidade e tempos de resposta muito menores, embora a sensibilidade possa variar conforme o painel de patógenos e fatores técnicos da coleta e processamento da amostra.
A adoção de diagnósticos moleculares mais amplos ainda enfrenta desafios, incluindo a necessidade de integração com fluxos clínicos estabelecidos e a interpretação dos resultados em conjunto com dados clínicos e laboratoriais tradicionais. Métodos genéticos de identificação, como sequenciamento metagenômico, demonstram potencial similar e podem complementar os painéis existentes no futuro, especialmente em casos complexos ou com múltiplos agentes infecciosos.
Especialistas em microbiologia clínica ressaltam que a velocidade na detecção de sinais de sepse e a capacidade de estratificar pacientes conforme o risco de positividade em hemoculturas são fundamentais para melhorar desfechos, reduzir permanência hospitalar e otimizar o uso de recursos sanitários, particularmente em unidades de terapia intensiva. O avanço proporcionado pelo teste molecular apresentado nesta análise multicêntrica reforça a importância de ferramentas diagnósticas inovadoras em um dos maiores desafios da medicina de urgência.
A comunidade científica segue avaliando o papel desses testes rápidos em protocolos clínicos, com expectativa de novos estudos que confirmem o impacto direto em mortalidade e custos hospitalares, além de investigações que relacionem resultados moleculares com resistência microbiana, biomarcadores inflamatórios e prognóstico a longo prazo.